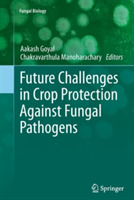
ibs

Future Challenges in Crop Protection Against Fungal Pathogens
This volume presents the issues and challenges of crop pathogens and plant protection. Composed of the latest knowledge in plant pathology, the book covers topics such as fungal diseases of the groundnut, plant growth promoting rhizobacteria, plant pathogenic fungi in the genomics era, the increased virulence of wheat rusts and oat fungal diseases. Written by experienced and internationally recognized scientists in the field, Future Challenges in Crop Protection Against Fungal Pathogens is a concise yet comprehensive resource valuable for both novice as well as experienced plant scientists and researchers.
-
Curatore:
-
Editore:
-
Collana:Fungal Biology
-
Anno:2016
-
Rilegatura:Paperback / softback
Le schede prodotto sono aggiornate in conformità al Regolamento UE 988/2023. Laddove ci fossero taluni dati non disponibili per ragioni indipendenti da Feltrinelli, vi informiamo che stiamo compiendo ogni ragionevole sforzo per inserirli. Vi invitiamo a controllare periodicamente il sito www.lafeltrinelli.it per eventuali novità e aggiornamenti.
Per le vendite di prodotti da terze parti, ciascun venditore si assume la piena e diretta responsabilità per la commercializzazione del prodotto e per la sua conformità al Regolamento UE 988/2023, nonché alle normative nazionali ed europee vigenti.
Per informazioni sulla sicurezza dei prodotti, contattare productsafety@feltrinelli.it